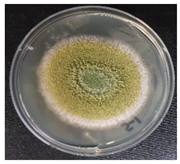
Jof 08 00190 i001 Jof 08 00190 i001

Aflatoxin Reduction and Retardation of Aflatoxin Production by Microorganisms in Doenjang during a One-Year Fermentation
Abstract
1. Introduction
2. Materials and Methods
2.1. Materials
2.2. Preparation of Doenjang
2.3. Artificial Contamination of Doenjang
2.3.1. Artificial Contamination of Commercial Aflatoxins
2.3.2. Artificial Contamination of A. flavus
2.4. Aflatoxin Extraction and HPLC Analysis
2.5. Aflatoxin Production by A. flavus at Different Stages of Doenjang Preparation
2.6. Aflatoxin Degradation by Microflora from Doenjang
2.7. Detection of Aflatoxin Production by Fungi Isolated from Doenjang
2.8. Effect of Salt Concentration on Aflatoxin-Producing Fungi
2.9. Molecular Identification of Microorganisms Isolated from Doenjang
2.10. Toxicity Analysis of Aflatoxin and Aflatoxin Degradation Products in Doenjang
2.10.1. Cells and Cell Culture
2.10.2. Extraction of Aflatoxin and Its Degradation Products form Doenjang
2.10.3. Toxicity Determination using Human Skin Fibroblast Cell Viability
2.11. Statistical Analyses
3. Results and Discussion
3.1. Aflatoxin Analysis in Non-Contaminated Doenjang during Fermentation
3.2. Aflatoxin Analysis in Artificially Contaminated Doenjang during Fermentation
3.3. Aflatoxin Production by A. flavus at Different Stages of Doenjang Preparation
3.4. Detection of Aflatoxins in Fungi Isolated from Doenjang
3.5. Effect of Salt on the Growth of Aflatoxin-Producing Fungi
3.6. Confirmation of Aflatoxin Degradation in Doenjang
3.7. Aflatoxin Degradation by the Microbial Consortium Obtained from Doenjang
3.8. Degradation of Aflatoxin by Microbial Isolates
3.9. Identification and Phylogenetic Analysis of the Isolated Microorganisms
3.10. Toxicity Determination in Human Skin Fibroblast Cells
4. Conclusions
Supplementary Materials
Author Contributions
Funding
Institutional Review Board Statement
Informed Consent Statement
Data Availability Statement
Conflicts of Interest
References
- Wang, D.; Wang, L.J.; Zhu, F.X.; Zhu, J.Y.; Chen, X.D.; Zou, L.; Saito, M. In vitro and in vivo studies on the antioxidant activities of the aqueous extracts of Douchi (a traditional Chinese salt-fermented soybean food). Food Chem. 2008, 107, 1421–1428. [Google Scholar] [CrossRef]
- Shukla, S.; Park, H.K.; Lee, J.S.; Kim, J.K.; Kim, M. Reduction of biogenic amines and aflatoxins in Doenjang samples fermented with various Meju as starter cultures. Food Control 2014, 42, 181–187. [Google Scholar] [CrossRef]
- Kuligowski, M.; Pawlowska, K.; Jasinska-Kuligowska, I.; Nowak, J. Isoflavone composition, polyphenols content and antioxidative activity of soybean seeds during tempeh fermentation. CYTA J. Food 2017, 15, 27–33. [Google Scholar] [CrossRef]
- Kim, T.W.; Lee, J.H.; Kim, S.E.; Park, M.H.; Chang, H.C.; Kim, H.Y. Analysis of microbial communities in doenjang, a Korean fermented soybean paste, using nested PCR-denaturing gradient gel electrophoresis. Int. J. Food Microbiol. 2009, 131, 265–271. [Google Scholar] [CrossRef] [PubMed]
- Xu, D.; Wang, P.; Zhang, X.; Zhang, J.; Sun, Y.; Gao, L.; Wang, W. High-throughput sequencing approach to characterize dynamic changes of the fungal and bacterial communities during the production of sufu, a traditional Chinese fermented soybean food. Food Microbiol. 2020, 86, 103340. [Google Scholar] [CrossRef]
- Jung, J.Y.; Lee, S.H.; Jeon, C.O. Microbial community dynamics during fermentation of doenjang-meju, traditional Korean fermented soybean. Int. J. Food Microbiol. 2014, 185, 112–120. [Google Scholar] [CrossRef]
- Hong, S.B.; Kim, D.H.; Samson, R.A. Aspergillus associated with Meju, a fermented soybean starting material for traditional soy sauce and soybean paste in Korea. Mycobiology 2015, 43, 218–224. [Google Scholar] [CrossRef]
- Ting, W.E.; Chang, C.H.; Szonyi, B.; Gizachew, D. Growth and aflatoxin B1, B2, G1, and G2 production by Aspergillus flavus and Aspergillus parasiticus on ground flax seeds (Linum usitatissimum). J. Food Prot. 2020, 83, 975–983. [Google Scholar] [CrossRef]
- Jeong, S.E.; Chung, S.H.; Hong, S.Y. Natural occurrence of aflatoxins and ochratoxin A in meju and soybean paste produced in South Korea. Appl. Biol. Chem. 2019, 62, 65. [Google Scholar] [CrossRef]
- IARC Working Group on the Evaluation of Carcinogenic Risks to Humans and International Agency for Research on Cancer. Some traditional herbal medicines, some mycotoxins, naphthalene and styrene. IARC Monogr. Eval. Carcinog. Risks Hum. 2002, 82, 171–249. [Google Scholar]
- Tian, F.; Lee, S.Y.; Woo, S.Y.; Choi, H.Y.; Park, S.B.; Chun, H.S. Effect of plant-based compounds on the antifungal and antiaflatoxigenic efficiency of strobilurins against Aspergillus flavus. J. Hazard. Mater. 2021, 415, 125663. [Google Scholar] [CrossRef]
- Shukla, S.; Lee, J.S.; Park, H.K.; Kim, J.K.; Kim, M. Effect of novel starter culture on reduction of biogenic amines, quality improvement, and sensory properties of doenjang, a traditional Korean soybean fermented sauce variety. J. Food Sci. 2015, 80, M1794–M1803. [Google Scholar] [CrossRef] [PubMed]
- Tamura, K.; Stecher, G.; Peterson, D.; Filipski, A.; Kumar, S. MEGA6: Molecular evolutionary genetics analysis version 6.0. Mol. Biol. Evol. 2013, 30, 2725–2729. [Google Scholar] [CrossRef] [PubMed]
- Bahuguna, A.; Khan, I.; Bajpai, V.K.; Kang, S.C. MTT assay to evaluate the cytotoxic potential of a drug. Bangladesh J. Pharmacol. 2017, 12, 115–118. [Google Scholar] [CrossRef]
- Kim, M.; Kim, Y.S. Detection of foodborne pathogens and analysis of aflatoxin levels in home-made doenjang samples. Prev. Nutr. Food Sci. 2012, 17, 172–176. [Google Scholar] [CrossRef] [PubMed][Green Version]
- Na, H.S. Survey of mycotoxin contents of Korean traditional fermented foods in Jeollanam-do. J. Korean Soc. Food Sci. Nutr. 2016, 251. Available online: https://www.koreascience.or.kr/article/JAKO202018853212248.pdf (accessed on 13 December 2021).
- Woo, S.Y.; Ryu, S.Y.; Tian, F.; Lee, S.Y.; Park, S.B.; Chun, H.S. Simultaneous determination of twenty mycotoxins in the Korean soybean paste doenjang by LC-MS/MS with immunoaffinity cleanup. Toxins 2019, 11, 594. [Google Scholar] [CrossRef]
- Bae, S.I.; Kwak, B.Y.; Park, Y.K.; Kim, Y.H.; Shon, D.H. Survey of aflatoxin B1 in domestic doenjang and kochujang determined by enzyme linked-immunosorbent assay. J. Food Hyg. Saf. 2003, 18, 95–100. [Google Scholar]
- Lee, G.I.; Lee, H.M.; Lee, C.H. Food safety issues in industrialization of traditional Korean foods. Food Control 2012, 24, 1–5. [Google Scholar] [CrossRef]
- Park, K.Y. Aflatoxin: Factors affecting aflatoxin production. J. Korean Soc. Food Sci. Nutr. 1984, 13, 117–126. [Google Scholar]
- Xu, D.; Wang, H.; Zhang, Y.; Yang, Z.; Sun, X. Inhibition of non-toxigenic Aspergillus niger FS10 isolated from Chinese fermented soybean on growth and aflatoxin B1 production by Aspergillus flavus. Food Control 2013, 32, 359–365. [Google Scholar] [CrossRef]
- Watanakij, N.; Visessanguan, W.; Petchkongkaew, A. Aflatoxin B1-degrading activity from Bacillus subtilis BCC 42005 isolated from fermented cereal products. Food Addit. Contam. Part A 2020, 37, 1579–1589. [Google Scholar] [CrossRef] [PubMed]
- Cho, K.M.; Math, R.K.; Hong, S.Y.; Islam, S.M.A.; Mandanna, D.K.; Cho, J.J.; Yun, M.G.; Kim, J.M.; Yun, H.D. Iturin produced by Bacillus pumilus HY1 from Korean soybean sauce (kanjang) inhibits growth of aflatoxin producing fungi. Food Control 2009, 20, 402–406. [Google Scholar] [CrossRef]
- Lee, K.R.; Yang, S.M.; Cho, S.M.; Kim, M.; Hong, S.Y.; Chung, S.H. Aflatoxin B1 detoxification by Aspergillus oryzae from meju, a traditional Korean fermented soybean starter. J. Microbiol. Biotechnol. 2017, 27, 57–66. [Google Scholar] [CrossRef]
- Lee, S.Y.; Woo, S.Y.; Ryu, S.Y.; Ok, H.E.; Chun, H.S. Aflatoxins in doenjang, a traditional Korean fermented soybean paste: A safety perspective. ACS Symp. Ser. 2019, 1303, 135–148. [Google Scholar]
- Tai, B.; Chang, J.; Liu, Y.; Xing, F. Recent progress of the effect of environmental factors on Aspergillus flavus growth and aflatoxins production on foods. Food Qual. Saf. 2020, 4, 21–28. [Google Scholar] [CrossRef]
- Giorni, P.; Battilani, P.; Pietri, A.; Magan, N. Effect of aw and CO2 level on Aspergillus flavus growth and aflatoxin production in high moisture maize post-harvest. Int. J. Food Microbiol. 2008, 122, 109–113. [Google Scholar] [CrossRef]
- Mousa, W.; Ghazali, F.M.; Jinap, S.; Ghazali, H.M.; Radu, S.; Salama, A.E.R. Temperature, water activity and gas composition effects on the growth and aflatoxin production by Aspergillus flavus on paddy. J. Stored Prod. Res. 2016, 67, 49–55. [Google Scholar] [CrossRef]
- Chitaree, K.; Kiatsompob, T.; Panchang, W.; Thanaboripat, D. Effect of salt concentrations on aflatoxin production in peanut by Aspergillus flavus. Agric. Nat. Resour. 1993, 27, 354–357. [Google Scholar]
- Bahuguna, A.; Shukla, S.; Lee, J.S.; Bajpai, V.K.; Kim, S.Y.; Huh, Y.S.; Han, Y.K.; Kim, M. Garlic augments the functional and nutritional behavior of Doenjang, a traditional Korean fermented soybean paste. Sci. Rep. 2019, 9, 5436. [Google Scholar] [CrossRef]
- Wei, R.D.; Chang, S.C.; Lee, S.S. High pressure liquid chromatographic determination of aflatoxins in soy sauce and fermented soybean paste. J. Assoc. Off. Anal. Chem. 1980, 63, 1269–1274. [Google Scholar] [CrossRef] [PubMed]
- Park, K.Y.; Lee, K.B.; Bullerman, L.B. Aflatoxin production by Aspergillus parasiticus and its stability during the manufacture of Korean soy paste (doenjang) and soy sauce (kanjang) by traditional method. J. Food Prot. 1988, 51, 938–944. [Google Scholar] [CrossRef]
- Petchkongkaew, A.; Taillandier, P.; Gasaluck, P.; Lebrihi, A. Isolation of Bacillus spp. from Thai fermented soybean (Thua-nao): Screening for aflatoxin B1 and ochratoxin A detoxification. J. Appl. Microbiol. 2008, 104, 1495–1502. [Google Scholar] [CrossRef] [PubMed]
- Rao, K.R.; Vipin, A.V.; Hariprasad, P.; Appaiah, K.A.; Venkateswaran, G.J.F.C. Biological detoxification of aflatoxin B1 by Bacillus licheniformis CFR1. Food Control 2017, 71, 234–241. [Google Scholar]
- Maxwell, L.A.; Callicott, K.A.; Bandyopadhyay, R.; Mehl, H.L.; Orbach, M.J.; Cotty, P.J. Degradation of aflatoxins B1 by atoxigenic Aspergillus flavus biocontrol agents. Plant Dis. 2021, 105, 2343–2350. [Google Scholar] [CrossRef] [PubMed]
- Qiu, T.; Wang, H.; Yang, Y.; Yu, J.; Ji, J.; Sun, J.; Zhang, S.; Sun, X. Exploration of biodegradation mechanism by AFB1-degrading strain Aspergillus niger FS10 and its metabolic feedback. Food Control 2021, 121, 107609. [Google Scholar] [CrossRef]
- Li, J.; Huang, J.; Jin, Y.; Wu, C.; Shen, D.; Zhang, S.; Zhou, R. Mechanism and kinetics of degrading aflatoxin B1 by salt tolerant Candida versatilis CGMCC 3790. J. Hazard. Mater. 2018, 359, 382–387. [Google Scholar] [CrossRef]
- Li, J.; Huang, J.; Jin, Y.; Wu, C.; Shen, D.; Zhang, S.; Zhou, R. Aflatoxin B1 degradation by salt tolerant Tetragenococcus halophilus CGMCC 3792. Food Chem. Toxicol. 2018, 121, 430–436. [Google Scholar] [CrossRef]
- Leitao, J.; Le Bars, J.; Bailly, J.R. Production of aflatoxin B 1 by Aspergillus ruber Thom and Church. Mycopathologia 1989, 108, 135–138. [Google Scholar] [CrossRef]
- Ryu, J.A.; Kim, E.; Yang, S.M.; Lee, S.; Yoon, S.R.; Jang, K.S.; Kim, H.Y. High-throughput sequencing of the microbial community associated with the physicochemical properties of meju (dried fermented soybean) and doenjang (traditional Korean fermented soybean paste). LWT-Food Sci. Technol. 2021, 146, 111473. [Google Scholar] [CrossRef]
- Han, D.M.; Chun, B.H.; Feng, T.; Kim, H.M.; Jeon, C.O. Dynamics of microbial communities and metabolites in ganjang, a traditional Korean fermented soy sauce, during fermentation. Food Microbiol. 2020, 92, 103591. [Google Scholar] [CrossRef] [PubMed]
- Jung, W.Y.; Jung, J.Y.; Lee, H.J.; Jeon, C.O. Functional characterization of bacterial communities responsible for fermentation of doenjang: A traditional Korean fermented soybean paste. Front. Microbiol. 2016, 7, 827. [Google Scholar] [CrossRef] [PubMed]
- Huang, Z.R.; Guo, W.L.; Zhou, W.B.; Li, L.; Xu, J.X.; Hong, J.L.; Liu, H.P.; Zeng, F.; Bai, W.D.; Liu, B.; et al. Microbial communities and volatile metabolites in different traditional fermentation starters used for Hong Qu glutinous rice wine. Food Res. Int. 2019, 121, 593–603. [Google Scholar] [CrossRef] [PubMed]
- Lee, L.; Heo, S.; Jeong, D.W. Fungal microbial community profiles of meju, solar salt, and doenjang using pyrosequencing. Microbiol. Biotechnol. Lett. 2019, 47, 354–358. [Google Scholar] [CrossRef]
- Samuel, M.S.; Sivaramakrishna, A.; Mehta, A. Degradation and detoxification of aflatoxin B1 by Pseudomonas putida. Int. Biodeterior. Biodegrad. 2014, 86, 202–209. [Google Scholar] [CrossRef]
- Eshelli, M.; Harvey, L.; Edrada-Ebel, R.; McNeil, B. Metabolomics of the bio-degradation process of aflatoxin B1 by actinomycetes at an initial pH of 6.0. Toxins 2015, 7, 439–456. [Google Scholar] [CrossRef]
- Afsharmanesh, H.; Perez-Garcia, A.; Zeriouh, H.; Ahmadzadeh, M.; Romero, D. Aflatoxin degradation by Bacillus subtilis UTB1 is based on production of an oxidoreductase involved in bacilysin biosynthesis. Food Control 2018, 94, 48–55. [Google Scholar] [CrossRef]








| Characteristics | Isolate YURM3 | Isolate YURM4 | Isolate YURM9 | |
|---|---|---|---|---|
| Surface view | ![]() | ![]() | ![]() | |
| Microscopic view | ![]() | ![]() | ![]() | |
| Identification (ITS sequencing) | Aspergillus flavus | Aspergillus ruber | Aspergillus flavus | |
| Growth temperature | 28 °C ± 2.0 | 28 °C ± 2.0 | 28 °C ± 2.0 | |
| Growth pH | 5.6 ± 0.2 | 5.6 ± 0.2 | 5.6 ± 0.2 | |
| Growth at different salt concentrations | 0% | +++++ | +++++ | +++++ |
| 12% | +++ | ++ | +++ | |
| 14% | No growth | No growth | No growth | |
| 16% | No growth | No growth | No growth | |
| 18% | No growth | No growth | No growth | |
| 20% | No growth | No growth | No growth | |
| Toxin production at different salt concentrations (µg/L) | 0% | 104.11 | 53.88 | 144.54 |
| 12% | 79.27 | 0 | 88.22 | |
| 14% | Not detected | Not detected | Not detected | |
| 16% | Not detected | Not detected | Not detected | |
| 18% | Not detected | Not detected | Not detected | |
| 20% | Not detected | Not detected | Not detected | |
Publisher’s Note: MDPI stays neutral with regard to jurisdictional claims in published maps and institutional affiliations. |
© 2022 by the authors. Licensee MDPI, Basel, Switzerland. This article is an open access article distributed under the terms and conditions of the Creative Commons Attribution (CC BY) license (https://creativecommons.org/licenses/by/4.0/).
Share and Cite
Kumar, V.; Bahuguna, A.; Ramalingam, S.; Lee, J.S.; Han, S.S.; Chun, H.S.; Kim, M. Aflatoxin Reduction and Retardation of Aflatoxin Production by Microorganisms in Doenjang during a One-Year Fermentation. J. Fungi 2022, 8, 190. https://doi.org/10.3390/jof8020190
Kumar V, Bahuguna A, Ramalingam S, Lee JS, Han SS, Chun HS, Kim M. Aflatoxin Reduction and Retardation of Aflatoxin Production by Microorganisms in Doenjang during a One-Year Fermentation. Journal of Fungi. 2022; 8(2):190. https://doi.org/10.3390/jof8020190
Chicago/Turabian StyleKumar, Vishal, Ashutosh Bahuguna, Srinivasan Ramalingam, Jong Suk Lee, Sung Soo Han, Hyang Sook Chun, and Myunghee Kim. 2022. "Aflatoxin Reduction and Retardation of Aflatoxin Production by Microorganisms in Doenjang during a One-Year Fermentation" Journal of Fungi 8, no. 2: 190. https://doi.org/10.3390/jof8020190
APA StyleKumar, V., Bahuguna, A., Ramalingam, S., Lee, J. S., Han, S. S., Chun, H. S., & Kim, M. (2022). Aflatoxin Reduction and Retardation of Aflatoxin Production by Microorganisms in Doenjang during a One-Year Fermentation. Journal of Fungi, 8(2), 190. https://doi.org/10.3390/jof8020190